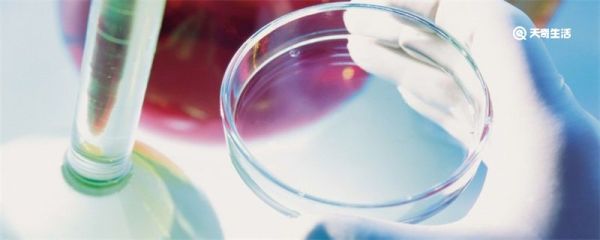
培养皿规格 常用培养皿规格

-

端午节吃粽子纪念谁 端午食粽为了纪念哪个人
端午节吃粽子是为了纪念伟大的爱国诗人——屈原。传说,当秦军攻破楚国都城之后,因无力救国而痛心不已的屈原选择了写下绝笔《怀沙》,抱石投江自尽。人们得知此事,纷纷来到江边划船打捞,却一无所获。为了不让江中...
2025-02-12阅读量:28
-

南瓜为什么与万圣节有关 为什么万圣节要扮鬼
万圣节,是一个充满神秘与奇幻色彩的节日。当夜幕降临,各种妖魔鬼怪开始在这个世界中游走,寻找乐趣。孩子们兴奋地穿上各式各样的鬼怪服装,提着南瓜灯,挨家挨户敲门索要糖果。那么,南瓜与万圣节有什么联系?下面...
2025-02-12阅读量:28
-

祝自己母亲节朋友圈说说 母亲节朋友圈说点什么
1、母亲节,只有真真的祝福,愿母亲健康永远,快乐常伴!今天也是我第一个母亲节,也祝自己节日快乐!2、不知不觉,我也是宝宝的母亲了,我也要过母亲节了。但是妈妈,我还是你的宝贝,你不能嫌弃我!3、祝妈妈同...
2025-02-12阅读量:28
-

海产品有哪些 海产品是海鲜吗
海产品指海洋中可供食用或使用的产品。范围非常的广泛。大多数指的是海生动物,海生植物。海藻类:发菜、紫菜、海带,虾类:龙虾、龙虾仔、基围虾等等。海产品生长于海中,环境相对洁净,食物也较为稳定不添加人工饲...
2025-02-12阅读量:30
-
培养皿规格 常用培养皿规格
常用的培养皿规格有直径为35mm、60mm、70mm、90mm、100mm、110mm、120mm、150mm等规格。培养皿是一种用于微生物或细胞培养的实验室器皿,由一个平面圆盘状的底和一个盖组成,一...
2025-02-12阅读量:27
-

三伏天每年从什么时候开始 三伏天的避暑常识
伏天是夏季中最热的时期,也是一年中最热的时候,这个时期,气温高、湿度大,人们容易感到闷热、疲惫和烦躁,在伏天,人们需要注意防暑降温,避免长时间暴露在高温下。那么三伏天每年从什么时间开始?跟着谜爱阁小编...
2025-02-12阅读量:27
-

退机票扣多少手续费 退机票手续费怎么收
首先是根据你买票的时候享受的折扣,退票手续费是不同的。享受的折扣越高,那么退票的手续费也会越高。其次,头等舱,经济舱的全价票是收取票价5%作为手续费,9-8折的机票收取票价的10%,7-5折的机票收取...
2025-02-12阅读量:26
-

左宗棠鸡是哪里的菜 左宗棠鸡是什么地方的菜
左宗棠鸡也称为左公鸡,是湖南省一道特色名菜,属于湘菜。该菜品在1952年由彭长贵创制,托名左宗棠,其实与清末将领左宗棠没有直接关系。左宗棠鸡选料严谨,制作精细。这道菜通常选用未下蛋的土鸡,鸡块去骨,经...
2025-02-12阅读量:31
-

上巳节是什么族的重要节日 上巳节是干什么的
上巳节是汉民族的重要节日。根据记载,春秋时期就有人过上巳了,这个节日在汉代以前有个很独特的风俗,它同时是政府为男女青年举办的狂欢节,《周礼·地官·媒氏》提到:“中春之月,令会男女。于是时也,奔者不禁。...
2025-02-12阅读量:31
-

中国煤矿文工团副团长什么级别 中国煤矿文工团获得的荣誉
中国煤矿文工团副团长是副厅级级别。中国煤矿文工团是集戏剧、音乐、舞蹈、曲艺等各种艺术门类为一体的综合性艺术院团,隶属于文化和旅游部。主要职责是创作演出优秀剧(节)目,服务基层,慰问群众。改革开放以后,...
2025-02-12阅读量:25
热门文章
1.酒精属于什么垃圾 酒精属于有害垃圾吗
- 1

- 酒精属于什么垃圾 酒精属于有害垃圾吗
- 2023-01-18
- 1
2.端午节吃咸鸭蛋的寓意 端午节吃咸鸭蛋的由来
- 2

- 端午节吃咸鸭蛋的寓意 端午节吃咸鸭蛋的由来
- 2022-12-21
- 2
3.佛教起源于 佛教起源于哪里
- 3

- 佛教起源于 佛教起源于哪里
- 2022-12-21
- 3
4.韩非子的寓言故事有哪些 韩非子中有那些著名的寓言故事
- 4

- 韩非子的寓言故事有哪些 韩非子中有那些著名的寓言故事
- 2023-01-19
- 4
5.活字印刷术为什么没有普及 为什么活字印刷术没有普及
- 5

- 活字印刷术为什么没有普及 为什么活字印刷术没有普及
- 2022-12-21
- 5
6.玉米油是色拉油吗 色拉油在超市叫什么
- 6

- 玉米油是色拉油吗 色拉油在超市叫什么
- 2022-12-21
- 6
7.中国的四大发明是 中国四大发明分别是什么
- 7

- 中国的四大发明是 中国四大发明分别是什么
- 2023-01-18
- 7
8.端午节为什么要赛龙舟 端午节赛龙舟的由来
- 8

- 端午节为什么要赛龙舟 端午节赛龙舟的由来
- 2022-12-21
- 8
9.第一个世界献血者日是哪年 第一个世界献血者日是哪年
- 9

- 第一个世界献血者日是哪年 第一个世界献血者日是哪年
- 2023-01-04
- 9
10.荔枝吃多了嗓子疼怎么办 荔枝吃多了嗓子疼咋办
- 10

- 荔枝吃多了嗓子疼怎么办 荔枝吃多了嗓子疼咋办
- 2023-01-05
- 10





